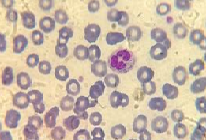
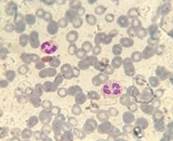
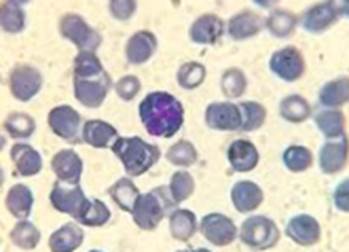

Déficit de MPO detectado por sistema PANDA. Reporte de un caso
Case report: MPO deficiency detected by PANDA system
Almirón, MN; Arias, M
Laboratorio de Hematología, Hemostasia y Citometría de Flujo. Hospital Dr. César Milstein
mauricionicolasalmiron@gmail.com
Palabras claves: mieloperoxidasa,
ADVIA,
déficit.
Keywords: deficiency,
myeloperoxidase,
ADVIA
Objetivos
v Mostrar y educar acerca de cómo el déficit de MPO puede conducir a informar resultados falsos en la fórmula leucocitaria cuando se utilizan equipos con sistema PANDA (Peroxidase activity and nuclear density analysis).
v Destacar la importancia del extendido de sangre periférica y la citoquímica en la rutina diaria.
Caso clínico
Paciente femenino de 88 años con diagnóstico de tumor maligno de colon en tratamiento oncológico. Acude a nuestro laboratorio para realizar un hemograma, que se lleva a cabo en el contador hematológico ADVIA 2120 de Siemens que utiliza sistema PANDA para realizar el diferencial de leucocitos. En él se observa una neutropenia severa, por lo que se decide hacer un frotis de sangre periférica coloreado con May Grünwald-Giemsa para confirmar el resultado, obteniéndose por este método una fórmula porcentual normal.
|
|
ADVIA 2120 (%) |
Microscopía óptica (%) |
|
Neutrófilos |
21 |
68 |
|
Linfocitos |
24 |
24 |
|
Monocitos |
52 |
6 |
|
Eosinófilos |
2 |
2 |
|
Basófilos |
1 |
0 |
En el gráfico de actividad de peroxidasa vs tamaño
celular obtenido en el ADVIA 2120 se observó lo siguiente (Gráfico 1):
Gráfico 1. Actividad de peroxidasa vs tamaño celular
de la muestra del paciente.

El mismo coincide con el patrón “P2” que es
característico de un paciente con déficit parcial de MPO (Gráfico 2).
Gráfico 2. Actividad de peroxidasa vs tamaño celular
típico para un paciente con déficit parcial de MPO.

Ante esta discrepancia se decide realizar la fórmula diferencial utilizando un DxH 800 de Beckman Coulter, que utiliza para obtener el diferencial tecnología VCS y, por otro lado, un contador hematológico Sysmex, que posee citometría de flujo (FSC vs SSC) para hacer la fórmula leucocitaria. Se obtuvieron los siguientes resultados (Tabla 1).
Tabla 1. Resultados del diferencial obtenidos por
equipos automatizados que difieren en la tecnología para realizar la fórmula leucocitaria.
|
|
DxH 800 (%) |
Sysmex (%) |
|
Neutrófilos |
64 |
58 |
|
Linfocitos |
25 |
29 |
|
Monocitos |
9 |
10 |
|
Eosinófilos |
2 |
3 |
|
Basófilos |
0 |
0 |
Debido a que los contadores hematológicos utilizados poseen diferentes tecnologías para realizar el diferencial de la fórmula leucocitaria, se decidió llevar a cabo una reacción citoquímica para MPO. En la misma se observó que los neutrófilos de la paciente carecían parcial o totalmente de peroxidasa (Figura 1).
Figura 1. Citoquímica para MPO. Obsérvese la ausencia
parcial o total de la actividad de MPO en los neutrófilos del paciente.

Paralelamente se llevó a cabo un control positivo de
MPO para validar la reacción (Figura 2).
Figura 2. Control de la reacción citoquímica
para MPO.
Con estos resultados podemos asegurar que el paciente presenta un déficit parcial de MPO en los neutrófilos, demostrado por diferentes metodologías (automatizada y manual) que confirman la sospecha inicial que surge al observar el patrón P2 característico que tienen estos pacientes.
Conclusión
ü Tener especial cuidado con las neutropenias relativas obtenidas de contadores hematológicos que utilicen PANDA para realizar el diferencial de leucocitos.
ü La inspección al microscopio óptico sigue siendo una herramienta fundamental en la práctica diaria de la hematología clínica.
ü La citoquímica de la MPO es una técnica sencilla y económica que debe estar disponible en la rutina, ya que brinda información valiosa en poco tiempo.
Bibliografía
1. Winterbourn CC, Vissers MC, Kettle AJ. Myeloperoxidase. Curr Opin Hematol. 2000;7:53-58.
2. Lanza F. Clinical manifestation of myeloperoxidase deficiency. J Mol Med. 1998;76:676-681.
3. Zini G, d’Onofrio G. Neural network in hematopoietic malignancies. Clin Chim Acta. 2003;333:195-201.
4. D’Onofrio G. PANDA: innovative classification of hematopoietic malignancies. Bloodline Rev. 2001;1:3-6.